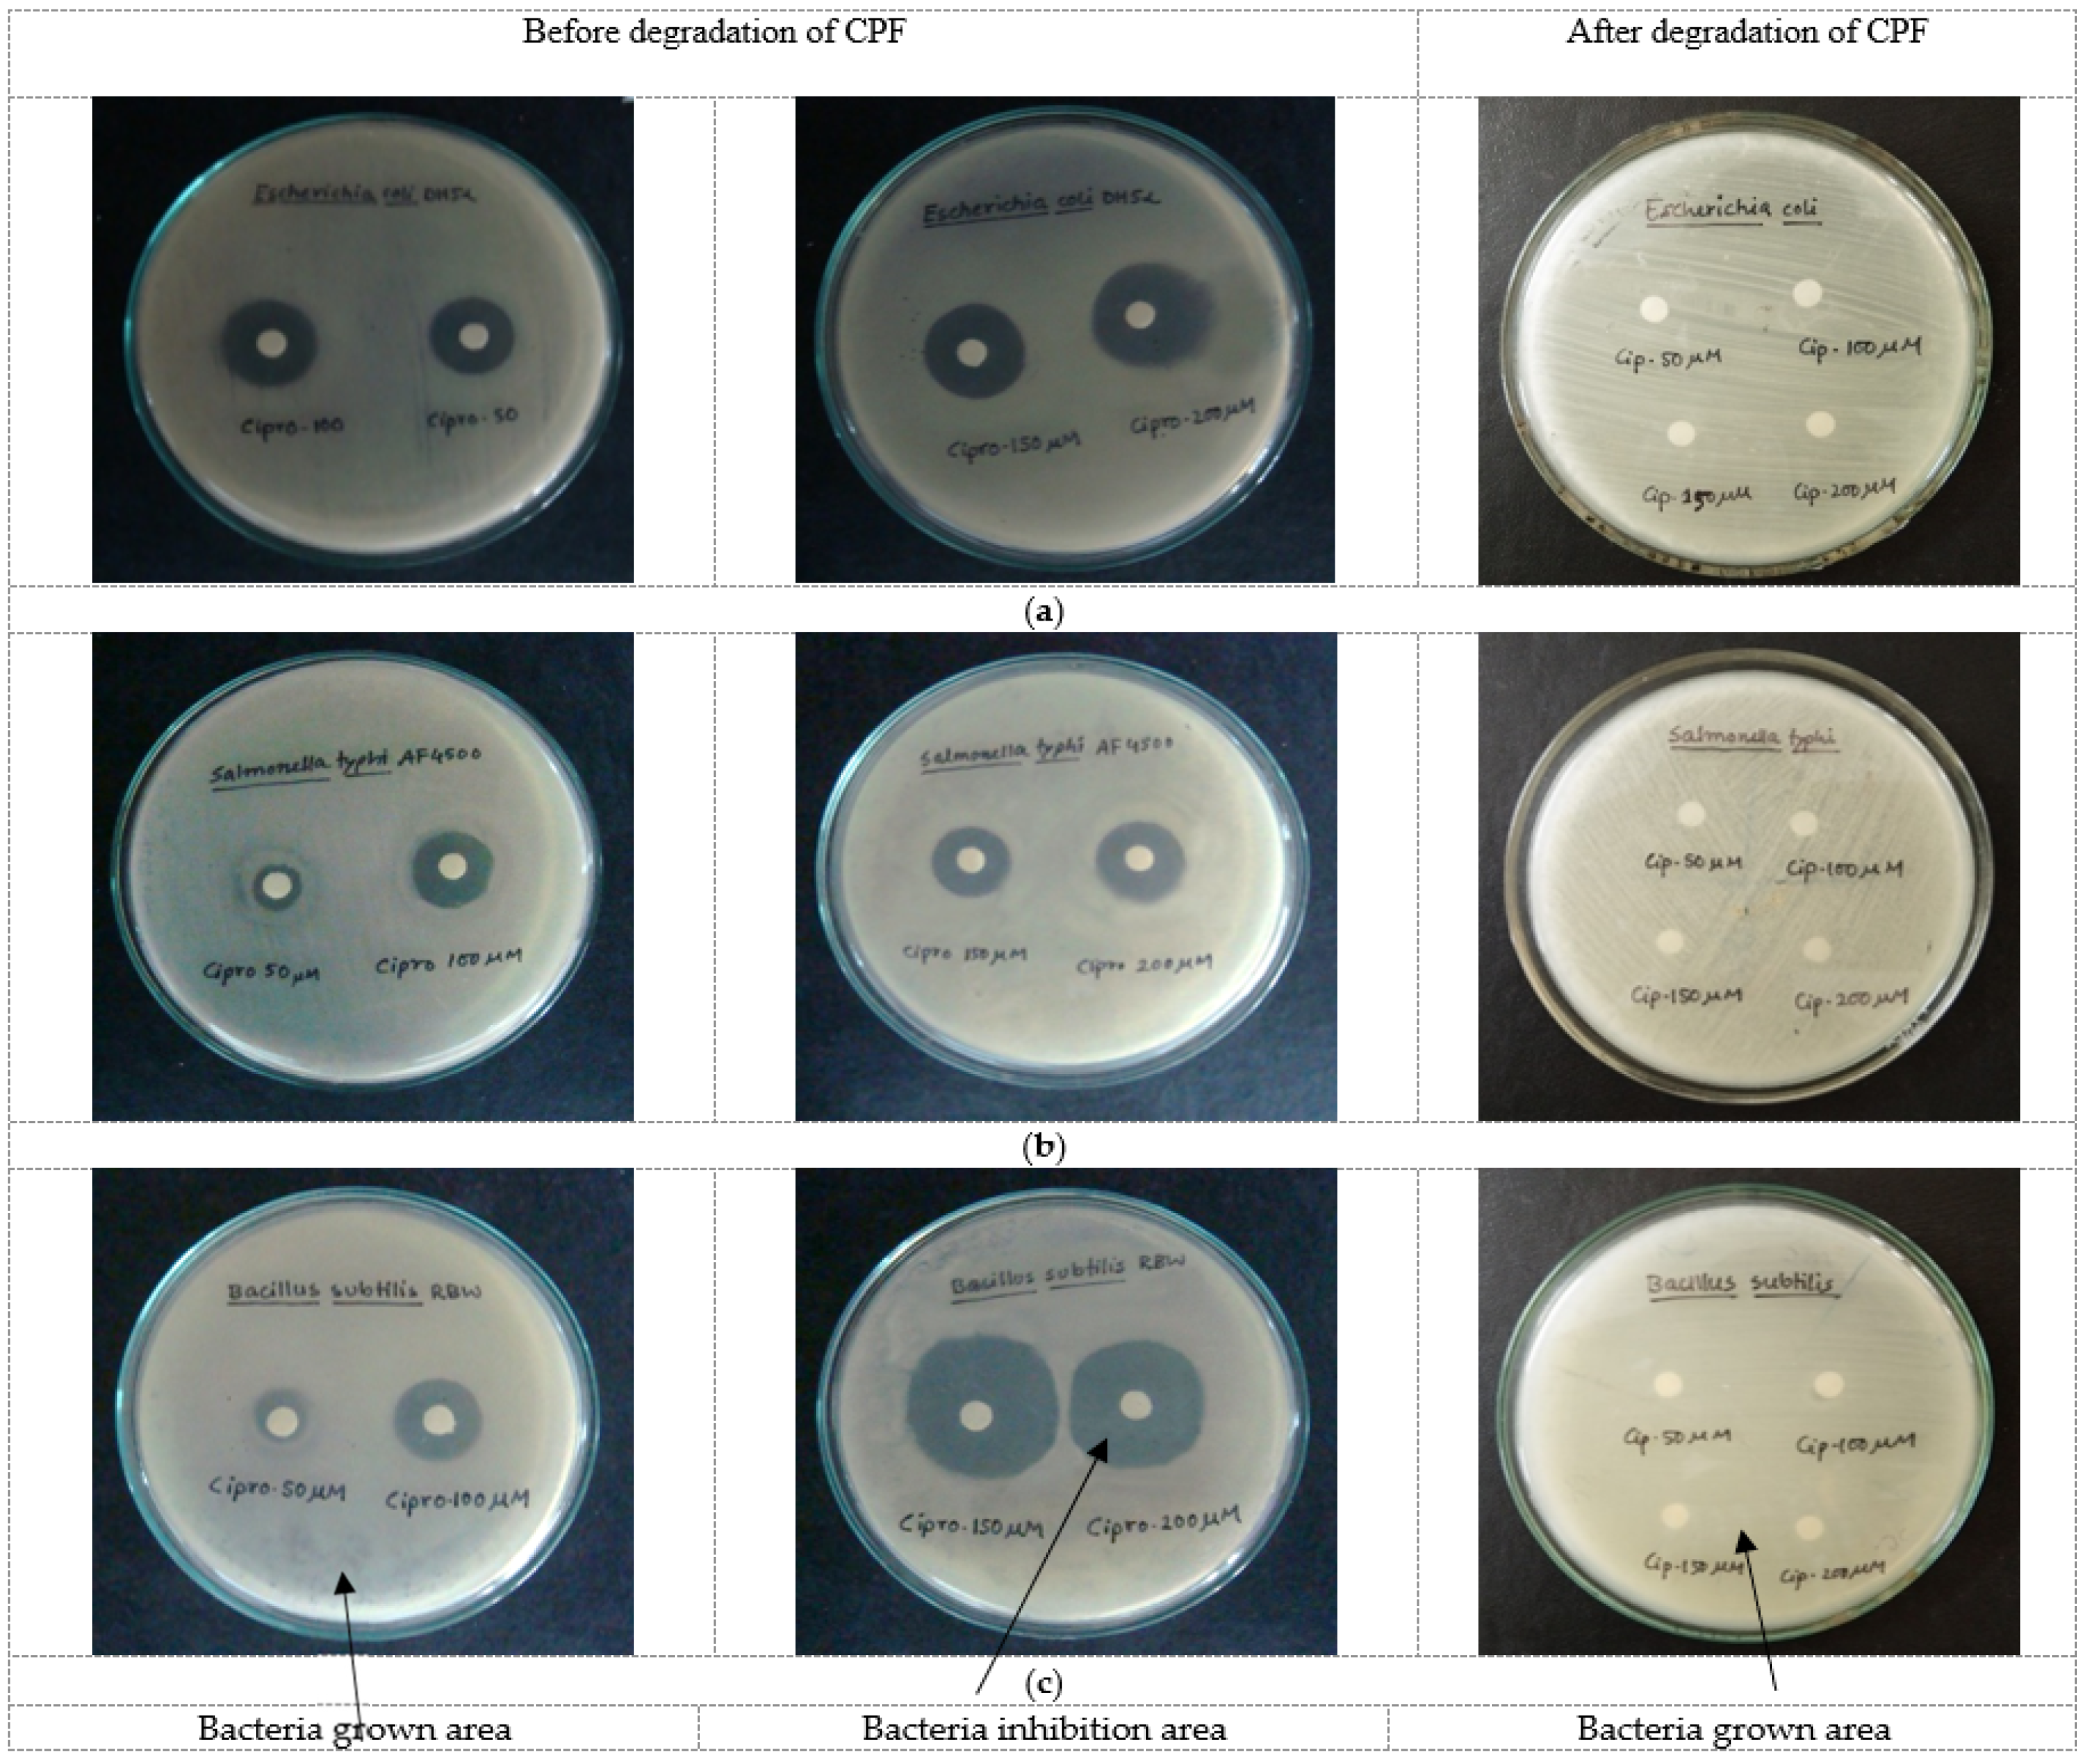
Catalysts 12 00475 g014

Solar Light-Assisted Oxidative Degradation of Ciprofloxacin in Aqueous Solution by Iron(III) Chelated Cross-Linked Chitosan Immobilized on a Glass Plate
Abstract
:1. Introduction
2. Results and Discussion
2.1. Characterization Results
2.1.1. FTIR Spectra
2.1.2. Mössbauer Spectroscopy
2.1.3. X-ray Diffraction (XRD)
2.1.4. Surface Morphology and Elemental Composition of FeIII-CS-GLA
2.2. Catalysis Results
2.2.1. Effect of Solar Light Irradiation
- (i)
- 50 µM CPF + CS-GLA immobilized on a glass plate + solar light;
- (ii)
- 50 µM CPF + FeIII-CS-GLA immobilized on a glass plate + solar light;
- (iii)
- 50 µM CPF + FeIII-CS-GLA immobilized on a glass plate + H2O2 + dark;
- (iv)
- 50 µM CPF + FeIII-CS-GLA immobilized on a glass plate + H2O2 + solar light
2.2.2. Effect of pH
2.2.3. Effect of GLA Dosage in FeIII-CS-GLA
2.2.4. Effect of Iron(III) Content in FeIII-CS-GLA
2.2.5. Effect of H2O2 Concentration
2.2.6. Effect of CPF Concentration
2.2.7. Effect of a Hydroxyl Radical Scavenger
2.2.8. Identification of the Oxidative Degradation Products of CPF
2.2.9. Antibacterial Activity of CPF before and after Catalytic Degradation
2.2.10. Reuse of the FeIII-CS-GLA Catalyst for Degradation of CPF in Aqueous Solution
3. Materials and Methods
3.1. Materials and Reagents
3.2. Preparation of Iron(III) Chelated Cross-Linked Chitosan, FeIII-CS-GLA, Immobilized on a Glass Plate
3.3. Characterization of FeIII-CS-GLA
3.4. FeIII-CS-GLA Catalyzed Batch Oxidative Degradation of CPF in Aqueous Solution
- (i)
- 50 µM CPF + CS-GLA immobilized on a glass plate + solar light;
- (ii)
- 50 µM CPF + Fe(III)-CS-GLA immobilized on a glass plate + solar light;
- (iii)
- 50 µM CPF + Fe(III)-CS-GLA immobilized on a glass plate + H2O2 + dark;
- (iv)
- 50 µM CPF + Fe(III)-CS-GLA immobilized on a glass plate + H2O2 + solar light.
3.5. Investigation of the Products of Oxidative CPF Degradation by HPLC-UV-ESI-MS
3.6. Assay for Antibacterial Activity Measurement
4. Conclusions
Supplementary Materials
Author Contributions
Funding
Acknowledgments
Conflicts of Interest
References
- Aslam, B.; Wang, W.; Arshad, M.I.; Khurshid, M.; Muzammil, S.; Rasool, M.H.; Nisar, M.A.; Alvi, R.F.; Aslam, M.A.; Qamar, M.U.; et al. Antibiotic resistance: A rundown of a global crisis. Infect. Drug Resist. 2018, 11, 1645–1658. [Google Scholar] [CrossRef] [PubMed] [Green Version]
- Rather, I.A.; Kim, B.C.; Bajpai, V.K.; Park, Y.-H. Self-medication and antibiotic resistance: Crisis, current challenges, and prevention. Saudi J. Biol. Sci. 2017, 24, 808–812. [Google Scholar] [CrossRef] [PubMed]
- Harrower, J.; McNaughtan, M.; Hunter, C.; Hough, R.; Zhang, Z.; Helwig, K. Chemical fate and partitioning behavior of antibiotics in the aquatic environment—A review. Environ. Toxicol. Chem. 2021, 40, 3275–3298. [Google Scholar] [CrossRef] [PubMed]
- Beek, T.A.D.; Weber, F.-A.; Bergmann, A.; Hickmann, S.; Ebert, I.; Hein, A.; Küster, A. Pharmaceuticals in the environment—Global occurrences and perspectives. Environ. Toxicol. Chem. 2016, 35, 823–835. [Google Scholar] [CrossRef]
- Gothwal, R.; Shashidhar, T. Antibiotic pollution in the environment: A review. Clean-Soil Air Water 2015, 43, 479–489. [Google Scholar] [CrossRef]
- Kuppusamy, S.; Kakarla, D.; Venkateswarlu, K.; Megharaj, M.; Yoon, Y.-E.; Lee, Y.B. Veterinary antibiotics (VAs) contamination as a global agro-ecological issue: A critical view. Agric. Ecosyst. Environ. 2018, 257, 47–59. [Google Scholar] [CrossRef]
- Zhu, Y.-G.; Johnson, T.A.; Su, J.-Q.; Qiao, M.; Guo, G.-X.; Stedtfeld, R.-D.; Hashsham, S.A.; Tiedje, J.M. Diverse and abundant antibiotic resistance genes in Chinese swine farms. Proc. Natl. Acad. Sci. USA 2013, 110, 3435–3440. [Google Scholar] [CrossRef] [Green Version]
- Munir, M.; Xagoraraki, I. Levels of antibiotic resistance genes in manure, biosolids, and fertilized soil. J. Environ. Qual. 2011, 40, 248–255. [Google Scholar] [CrossRef] [Green Version]
- Wang, Q.; Wang, P.; Yang, Q. Occurrence and diversity of antibiotic resistance in untreated hospital wastewater. Sci. Total Environ. 2018, 621, 990–999. [Google Scholar] [CrossRef]
- Lorenzo, P.; Adriana, A.; Jessica, S.; Carles, B.; Marinella, F.; Marta, L.; Luis, B.J.; Pierre, S. Antibiotic resistance in urban and hospital wastewaters and their impact on a receiving freshwater ecosystem. Chemosphere 2018, 206, 70–82. [Google Scholar] [CrossRef]
- Zhang, M.; Meng, J.; Liu, Q.; Gu, S.; Zhao, L.; Dong, M.; Zhang, J.; Hou, H.; Guo, Z. Corn stover–derived biochar for efficient adsorption of oxytetracycline from wastewater. J. Mater. Res. 2019, 34, 3050–3060. [Google Scholar] [CrossRef] [Green Version]
- Fu, H.; Li, X.; Wang, J.; Lin, P.; Chen, C.; Zhang, X.; Suffet, I.H. Activated carbon adsorption of quinolone antibiotics in water: Performance, mechanism, and modeling. J. Environ. Sci. 2017, 56, 145–152. [Google Scholar] [CrossRef] [PubMed]
- Cuerda-Correa, E.M.; Alexandre-Franco, M.F.; Fernandez-Gonzalez, C. Advanced oxidation process for the removal of antibiotics from water. An overview. Water 2020, 12, 102. [Google Scholar] [CrossRef] [Green Version]
- Liu, P.; Wu, Z.; Abramova, A.V.; Cravotto, G. Sonochemical processes for the degradation of antibiotics in aqueous solution: A review. Ultrason. Sonochem. 2021, 74, 105566. [Google Scholar] [CrossRef] [PubMed]
- Wang, J.; Zhuan, R.; Chu, L. The occurrence, distribution and degradation of antibiotics by ionizing radiation: An overview. Sci. Total Environ. 2019, 646, 1385–1397. [Google Scholar] [CrossRef]
- Xu, Y.; Liu, J.; Xie, M.; Jing, L.; Xu, H.; She, X.; Li, H.; Xie, J. Construction of novel CNT/LaVO4 nanostructures for efficient antibiotic photodegradation. Chem. Eng. J. 2019, 357, 487–497. [Google Scholar] [CrossRef]
- Iakovides, I.C.; Michael-Kordatou, I.; Moreira, N.F.F.; Ribeiro, A.R.; Fernandes, T.; Pereira, M.F.R.; Nunes, O.C.; Manaia, C.M.; Silva, A.M.T.; Fatta-Kassinos, D. Continuous ozonation of urban wastewater: Removal of antibiotics, antibiotic-resistant Escherichia coli and antibiotic resistance genes and phytotoxicity. Water Res. 2019, 159, 333–347. [Google Scholar] [CrossRef]
- Guo, M.-T.; Yuan, Q.-B.; Yang, J. Distinguishing effects of ultraviolet exposure and chlorination on the horizontal transfer of antibiotic resistance genes in municipal wastewater. Environ. Sci. Technol. 2015, 49, 5771–5778. [Google Scholar] [CrossRef]
- Lan, L.; Kong, X.; Sun, H.; Li, C.; Liu, D. High removal efficiency of antibiotic resistance genes in swine wastewater via nanofiltration and reverse osmosis processes. J. Environ. Manag. 2019, 231, 439–445. [Google Scholar] [CrossRef]
- Li, N.; Sheng, G.-P.; Lu, Y.-Z.; Zeng, R.J.; Yu, H.-Q. Removal of antibiotic resistance genes from wastewater treatment plant effluent by coagulation. Water Res. 2017, 111, 204–212. [Google Scholar] [CrossRef]
- Parvulescu, V.I.; Epron, F.; Garcia, H.; Granger, P. Recent progress and prospects in catalytic water treatment. Chem. Rev. 2022, 122, 2981–3121. [Google Scholar] [CrossRef] [PubMed]
- Mathur, P.; Sanyal, D.; Callahan, D.L.; Conlan, X.A.; Pfeffer, F.M. Treatment technologies to mitigate the harmful effects of recalcitrant fluoroquinolone antibiotics on the environment and human health. Environ. Pollut. 2021, 291, 118233. [Google Scholar] [CrossRef] [PubMed]
- Fantin, B.; Duval, X.; Massias, L.; Alavoine, L.; Chau, F.; Retout, S.; Andremont, A.; Mentre, F. Ciprofloxacin dosage and emergence of resistance in human commensal bacteria. J. Infect. Dis. 2009, 200, 390–398. [Google Scholar] [CrossRef] [PubMed]
- Khan, G.J.; Khan, R.A.; Majeed, I.; Siddiqui, F.A.; Khan, S. Ciprofloxacin; the frequent use in poultry and its consequences on human health. Professional Med. J. 2015, 22, 001–005. [Google Scholar] [CrossRef]
- Fasugba, O.; Gardner, A.; Mitchell, B.G.; Mnatzaganian, G. Ciprofloxacin resistance in community- and hospital-acquired Escherichia coli urinary tract infection: A systematic review and meta-analysis of observational studies. BMC Infect. Dis. 2015, 15, 545. [Google Scholar] [CrossRef] [Green Version]
- Canada-Canada, F.; de la Peña, A.M.; Espinosa-Mansilla, A. Analysis of antibiotics in fish samples. Anal. Bioanal. Chem. 2009, 395, 987–1008. [Google Scholar] [CrossRef]
- Zhang, Y.; Teng, Y.; Qin, Y.; Ren, Z.; Wang, Z. Determination of ciprofloxacin in fish by surface-enhanced raman scattering using a liquid-liquid self-assembled gold nanofilm. Anal. Lett. 2020, 53, 660–670. [Google Scholar] [CrossRef]
- Jiang, W.-T.; Chang, P.-H.; Wang, Y.-S.; Tsai, Y.; Jean, J.-S.; Li, Z.; Krukowski, K. Removal of ciprofloxacin from water by birnessite. J. Hazard. Mater. 2013, 250, 362–369. [Google Scholar] [CrossRef]
- Zaviska, F.; Drogui, P.; Grasmick, A.; Azais, A.; Heran, M. Nanofiltration membrane bioreactor for removing pharmaceutical compounds. J. Membr. Sci. 2013, 429, 121–129. [Google Scholar] [CrossRef]
- Ye, J.-S.; Liu, J.; Ou, H.-S.; Wang, L.-L. Degradation of ciprofloxacin by 280 nm ultraviolet-activated persulfate: Degradation pathway and intermediate impact on proteome of Escherichia coli. Chemosphere 2016, 165, 311–319. [Google Scholar] [CrossRef]
- Matzek, L.W.; Tipton, M.J.; Farmer, A.T.; Steen, A.D.; Carter, K.E. Understanding electrochemically activated persulfate and its application to ciprofloxacin abatement. Environ. Sci. Technol. 2018, 52, 5875–5883. [Google Scholar] [CrossRef] [PubMed]
- Malakootian, M.; Ahmadian, M. Removal of ciprofloxacin from aqueous solution by electro-activated persulfate oxidation using aluminum electrodes. Water Sci. Technol. 2019, 80, 587–596. [Google Scholar] [CrossRef] [PubMed]
- Bel, E.D.; Dewulf, J.; Witte, B.D.; Langenhove, H.V.; Janssen, C. Influence of pH on the sonolysis of ciprofloxacin: Biodegradability, ecotoxicity and antibiotic activity of its degradation products. Chemosphere 2009, 77, 291–295. [Google Scholar] [CrossRef] [PubMed]
- Luo, L.; Zou, D.; Lu, D.; Xin, B.; Zhou, M.; Zhai, X.; Ma, J. Heterogeneous catalytic ozonation of ciprofloxacin in aqueous solution using a manganese-modified silicate ore. RSC Adv. 2018, 8, 33534. [Google Scholar] [CrossRef] [Green Version]
- Yang, H.; Li, Y.; Chen, Y.; Ye, G.; Sun, X. Comparison of ciprofloxacin degradation in reclaimed water by UV/chlorine and UV/persulfate advanced oxidation processes. Water Environ. Res. 2019, 91, 1576–1588. [Google Scholar] [CrossRef]
- Bobu, M.; Yediler, A.; Siminiceanu, I.; Schulte-Hostede, S. Degradation studies of ciprofloxacin on a pillared iron catalyst. Appl. Catal. B-Environ. 2008, 83, 15–23. [Google Scholar] [CrossRef]
- Gupta, A.; Garg, A. Degradation of ciprofloxacin using Fenton’s oxidation: Effect of operating parameters, identification of oxidized by-products and toxicity assessment. Chemosphere 2018, 193, 1181–1188. [Google Scholar] [CrossRef]
- de Lima Perini, J.A.; Perez-Moya, M.; Nogueira, R.F.P. Photo-Fenton degradation kinetics of low ciprofloxacin concentration using different iron sources and pH. J. Photochem. Photobiol. A 2013, 259, 53–58. [Google Scholar] [CrossRef]
- Diao, Z.-H.; Xu, X.-R.; Jiang, D.; Li, G.; Liu, J.-J.; Kong, L.-J.; Zuo, L.-Z. Enhanced catalytic degradation of ciprofloxacin with FeS2/SiO2 microspheres as heterogeneous Fenton catalyst: Kinetics, reaction pathways and mechanism. J. Hazard. Mater. 2017, 327, 108–115. [Google Scholar] [CrossRef]
- Torniainen, K.; Tammilehto, S.; Ulvi, V. The effect of pH, buffer type and drug concentration on the photodegradation of ciprofloxacin. Int. J. Pharm. 1996, 132, 53–61. [Google Scholar] [CrossRef]
- El-Kemary, M.; El-Shamy, H.; El-Mehasseb, I. Photocatalytic degradation of ciprofloxacin drug in water using ZnO nanoparticles. J. Lumin. 2010, 130, 2327–2331. [Google Scholar] [CrossRef]
- Yan, Y.; Sun, S.; Song, Y.; Yan, X.; Guan, W.; Liu, X.; Shi, W. Microwave-assisted in situ synthesis of reduced graphene oxide-BiVO4 composite photocatalysts and their enhanced photocatalytic performance for the degradation of ciprofloxacin. J. Hazard. Mater. 2013, 250, 106–114. [Google Scholar] [CrossRef] [PubMed]
- Gad-Allah, T.A.; Ali, M.E.M.; Badawy, M.I. Photocatalytic oxidation of ciprofloxacin under simulated sunlight. J. Hazard. Mater. 2011, 186, 751–755. [Google Scholar] [CrossRef] [PubMed]
- Malakootian, M.; Nasiri, A.; Gharaghani, M.A. Photocatalytic degradation of ciprofloxacin antibiotic by TiO2 nanoparticles immobilized on a glass plate. Chem. Eng. Commun. 2020, 207, 56–72. [Google Scholar] [CrossRef]
- Kaur, A.; Anderson, W.A.; Tanvir, S.; Kansal, S.K. Solar light active silver/iron oxide/zinc oxide heterostructure for photodegradation of ciprofloxacin, transformation products and antibacterial activity. J. Colloid Interface Sci. 2019, 557, 236–253. [Google Scholar] [CrossRef]
- Lee, Y.; Lee, W. Degradation of trichloroethylene by Fe(II) chelated with cross-linked chitosan in a modified Fenton reaction. J. Hazard. Mater. 2010, 178, 187–193. [Google Scholar] [CrossRef]
- Marques Neto, J.d.O.; Bellato, C.R.; Milagres, J.L.; Pessoa, K.D.; de Alvarenga, E.S. Preparation and evaluation of chitosan beads immobilized with Iron(III) for the removal of As(III) and As(V) from water. J. Braz. Chem. Soc. 2013, 24, 121–132. [Google Scholar] [CrossRef] [Green Version]
- Trung, T.S.; Thein-Han, W.W.; Qui, N.T.; Ng, C.-H.; Stevens, W.F. Functional characteristics of shrimp chitosan and its membranes as affected by the degree of deacetylation. Bioresour. Technol. 2006, 97, 659–663. [Google Scholar] [CrossRef]
- Queiroz, M.F.; Melo, K.R.T.; Sabry, D.A.; Sassaki, G.L.; Rocha, H.A.O. Does the use of chitosan contribute to oxalate kidney stone formation? Mar. Drugs 2015, 13, 141–158. [Google Scholar] [CrossRef]
- Hernandez, R.B.; Franco, A.P.; Yola, O.R.; Lopez-Delgado, A.; Felcman, J.; Recio, M.A.L.; Merce, A.L.R. Coordination study of chitosan and Fe3+. J. Mol. Struct. 2008, 877, 89–99. [Google Scholar] [CrossRef]
- Gütlich, P. Fifty Years of Mossbauer Spectroscopy in Solid State Research—Remarkable Achievements, Future Perspectives. Z. Anorg. Allg. Chem. 2012, 638, 15–43. [Google Scholar] [CrossRef]
- Chiessi, E.; Paradossi, G.; Venanzzi, M.; Pispisa, B. Association complexes between Fe(III) or Cu(II) ions and chitosan derivatives. A thermodynamic and spectroscopic investigation. Int. J. Biol. Macromol. 1993, 15, 145–151. [Google Scholar] [CrossRef]
- Bhatia, S.C.; Ravi, N. A magnetic study of a Fe-chitosan complex and its relevance to other biomolecules. Biomacromolecules 2000, 1, 413–417. [Google Scholar] [CrossRef] [PubMed]
- Webster, A.; Halling, M.D.; Grant, D.M. Metal complexation of chitosan and its glutaraldehyde cross-linked derivative. Carbohydr. Res. 2007, 342, 1189–1201. [Google Scholar] [CrossRef] [PubMed]
- Zhu, H.-Y.; Xiao, L.; Jiang, R.; Zeng, G.-M.; Liu, L. Efficient decolorization of azo dye solution by visible light-induced photocatalytic process using SnO2/ZnO heterojunction immobilized in chitosan matrix. Chem. Eng. J. 2011, 172, 746–753. [Google Scholar] [CrossRef]
- Saha, T.K.; Ichikawa, H.; Fukumori, Y. Gadolinium diethylenetriaminopentaacetic acid-loaded chitosan microspheres for gadolinium neutron-capture therapy. Carbohydr. Res. 2006, 341, 2835–2841. [Google Scholar] [CrossRef]
- Katsumata, H.; Kaneco, S.; Suzuki, T.; Ohta, K.; Yobiko, Y. Photo-Fenton degradation of alachlor in the presence of citrate solution. J. Photochem. Photobiol. A 2006, 180, 38–45. [Google Scholar] [CrossRef]
- Feng, J.; Hu, X.; Yue, P.L.; Zhu, H.Y.; Lu, G.Q. Degradation of Azo-dye orange II by a photoassisted Fenton reaction using a novel composite of iron oxide and silicate nanoparticles as a catalyst. Ind. Eng. Chem. Res. 2003, 42, 2058–2066. [Google Scholar] [CrossRef]
- Feng, J.; Hu, X.; Yue, P.L.; Zhu, H.Y.; Lu, G.Q. Discoloration and mineralization of reactive red HE-3B by heterogeneous photo-Fenton reaction. Water Res. 2003, 37, 3776–3784. [Google Scholar] [CrossRef]
- Sum, O.S.N.; Feng, J.; Hu, X.; Yue, P.L. Pillared laponite clay-based Fe nanocomposites as heterogeneous catalysts for photo-Fenton degradation of acid black 1. Chem. Eng. Sci. 2004, 59, 5269–5275. [Google Scholar]
- Tamimi, M.; Qoural, S.; Barka, N.; Assabbane, A.; Ait-Ichou, Y. Methomyl degradation in aqueous solutions by Fenton’s reagent and the photo-Fenton system. Sep. Purif. Technol. 2008, 61, 103–108. [Google Scholar] [CrossRef]
- Pouretedal, H.R.; Kadkhodaie, A. Synthetic CeO2 nanoparticle catalysis of methylene blue photodegradation: Kinetics and mechanism. Chin. J. Catal. 2010, 31, 1328–1334. [Google Scholar] [CrossRef]
- Desesso, J.M.; Scialli, A.R.; Goeringer, G.C. D-Mannitol, a specific hydroxyl free radical scavenger, reduces the developmental toxicity of hydroxyurea in rabbits. Teratology 1994, 49, 248–259. [Google Scholar] [CrossRef] [PubMed]
- Bill, E. Mfit; Max–Planck Institute for Chemical Energy Conversion: Mülheim/Ruhr, Germany, 2008. [Google Scholar]
- Saha, T.K.; Frauendorf, H.; John, M.; Dechert, S.; Meyer, F. Efficient oxidative degradation of azo dyes by a water-soluble manganese porphyrin catalyst. ChemCatChem 2013, 5, 796–805. [Google Scholar] [CrossRef]
- Sarker, S.R.; Polash, S.A.; Boath, J.; Kandjani, A.E.; Poddar, A.; Dekiwadia, C.; Shukla, R.; Sabri, Y.; Bhargava, S.K. Functionalization of elongated tetrahexahedral Au nanoparticles and their antimicrobial activity assay. ACS Appl. Mater. Interfaces 2019, 11, 13450–13459. [Google Scholar] [CrossRef]

| Degradation Process | pH | kobs (min–1) | References |
|---|---|---|---|
| Sonolysis | 3 | 0.0210 | [33] |
| Pillared iron catalyst (Fe-Lap-RD) | 3 | 0.0253 | [36] |
| ZnO nanopartices | 4 | 0.0117 | [41] |
| Commercial anatase TiO2 | 3 | 0.0210 | [43] |
| Ag/Fe2O3/ZnO heterostructures | 4 | 0.0051 | [45] |
| FeIII-CS-GLA/H2O2 | 3 | 0.0134 | This work |
| No. | t(R) min | m/z | Elemental Composition | Proposed Compound |
|---|---|---|---|---|
| 1 | 2.5 | 147.0300 [M-H]− 129.0194 [M-H-H2O]− | C5H7O5 C5H5O4 | C5H8O5 Hydroxy-pentanedioic acid |
| 2 | 3.0 | 117.0195 [M-H]− | C4H5O4 | C4H6O4 Butanedioic acid |
| 3 | 4.0 | 131.0350 [M-H]− | C5H7O4 | C5H8O4 Pentanedioic acid |
| Concentration of CPF (μM) | Zone of Inhibition (mm) for Test Bacteria | ||
|---|---|---|---|
| Escherichia coli DH5α | Salmonella typhi AF4500 | Bacillus subtilis RBW | |
| Before catalytic degradation of CPF | |||
| 50 | 16.20 ± 0.40 | 10.00 ± 0.72 | 9.30 ± 1.10 |
| 100 | 18.10 ± 0.72 | 13.40 ± 0.68 | 16.60 ± 0.20 |
| 150 | 19.60 ± 0.50 | 15.10 ± 0.56 | 22.20 ± 0.10 |
| 200 | 20.40 ± 0.71 | 24.30 ± 0.40 | 25.10 ± 0.98 |
| After catalytic degradation of CPF | |||
| 50 | Not detected | Not detected | Not detected |
| 100 | Not detected | Not detected | Not detected |
| 150 | Not detected | Not detected | Not detected |
| 200 | Not detected | Not detected | Not detected |
Publisher’s Note: MDPI stays neutral with regard to jurisdictional claims in published maps and institutional affiliations. |
© 2022 by the authors. Licensee MDPI, Basel, Switzerland. This article is an open access article distributed under the terms and conditions of the Creative Commons Attribution (CC BY) license (https://creativecommons.org/licenses/by/4.0/).
Share and Cite
Saha, S.; Saha, T.K.; Karmaker, S.; Islam, Z.; Demeshko, S.; Frauendorf, H.; Meyer, F. Solar Light-Assisted Oxidative Degradation of Ciprofloxacin in Aqueous Solution by Iron(III) Chelated Cross-Linked Chitosan Immobilized on a Glass Plate. Catalysts 2022, 12, 475. https://doi.org/10.3390/catal12050475
Saha S, Saha TK, Karmaker S, Islam Z, Demeshko S, Frauendorf H, Meyer F. Solar Light-Assisted Oxidative Degradation of Ciprofloxacin in Aqueous Solution by Iron(III) Chelated Cross-Linked Chitosan Immobilized on a Glass Plate. Catalysts. 2022; 12(5):475. https://doi.org/10.3390/catal12050475
Chicago/Turabian StyleSaha, Soma, Tapan Kumar Saha, Subarna Karmaker, Zinia Islam, Serhiy Demeshko, Holm Frauendorf, and Franc Meyer. 2022. "Solar Light-Assisted Oxidative Degradation of Ciprofloxacin in Aqueous Solution by Iron(III) Chelated Cross-Linked Chitosan Immobilized on a Glass Plate" Catalysts 12, no. 5: 475. https://doi.org/10.3390/catal12050475
APA StyleSaha, S., Saha, T. K., Karmaker, S., Islam, Z., Demeshko, S., Frauendorf, H., & Meyer, F. (2022). Solar Light-Assisted Oxidative Degradation of Ciprofloxacin in Aqueous Solution by Iron(III) Chelated Cross-Linked Chitosan Immobilized on a Glass Plate. Catalysts, 12(5), 475. https://doi.org/10.3390/catal12050475

